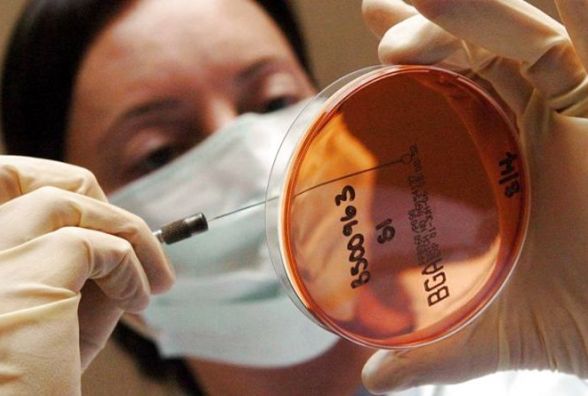

В Україну завезли польську курятину заражену сальмонелою
Автор:
Тетяна Шпікула
- Будьте обережні. Партія замороженого м'яса птиці механічного обвалювання від польського виробника Rolnicza Spoldzielnia Produkcyjna, Rojewo, містить сальмонелу.
Головне управління Держпродспоживслужби в Тернопільській області доводить до відома про отримання інформаційного повідомлення системи RASFF від 27 травня 2021 року № 2021.2582-fup1 стосовно виявлення Salmonella Enteritidis у курятині, що експортувалась з Польщі (виробник: Rolnicza Spoldzielnia Produkcyjna, Rojewo; відправник: Mitmar Sp. z o.o., Glowno), після чого зазначену продукцію перероблено на м’ясо механічного обвалювання та надіслано до України (отримувач: ТОВ «Фішзахід», вул. Городоцька, 355Г, м. Львів, 79040).
Просимо негайно повідомити Головне управління Держпродспоживслужби в Тернопільській області про виявлення даного продукту в обігу (м. Тернопіль, вул. Микулинецька, 20, тел. (0352) 52-10-10).
Довідка: Сальмонела — рід грам-негативних бактерій, родини ентеробактерій, що спричинюють черевний тиф, паратифи і сальмонельози.
Сальмонели стійкі до дії високих температур – для повної гарантії знищення сальмонел у шматках м’яса вагою 200– 300 грамів його необхідно варити протягом 2,5–3,5 годин.
Читайте також: Тиждень без м'яса: чи вплинув експеримент на стан крові та як без м'яса люди живуть роками




